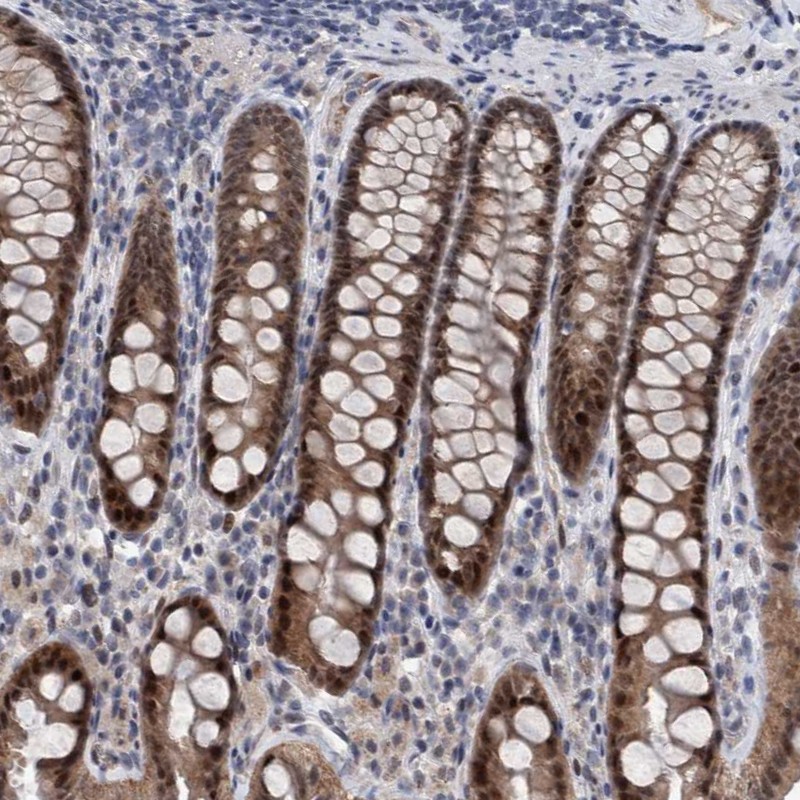
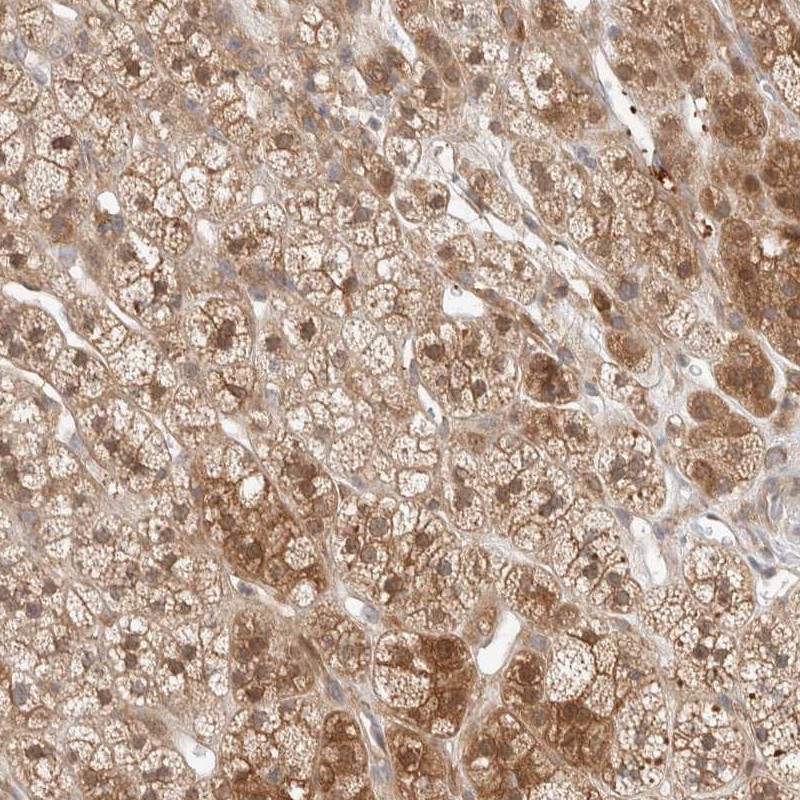

Filteroptionen
Kategorien
Hersteller
- ABP Biosciences (89)
- ABclonal (14295)
- ALPCO (4)
- ARP American Research Products (16)
- Abbexa (150570)
- Abbkine Scientific (114)
- Abcepta (97941)
- Abeomics (15363)
- Abnova (71465)
- Absolute Antibody (37307)
- AcroBiosystems (1015)
- Active Motif (1692)
- Affinity Biosciences (16910)
- Agdia EMEA (8)
- Agrisera (2456)
- Alpha Diagnostic (3588)
- AlphaThera (118)
- Ampersand Biosciences (50)
- Anogen-Yes Biotech Laboratories (397)
- Antibodies Incorporated (2753)
- Antibodies.com (117656)
- ApexBio (6387)
- Apop Biosciences (5)
- Aptum Biologics (15)
- Arbor Assays (22)
- Arlington Scientific (15)
- Assay Biotechnology (21377)
- Atlas Antibodies (23680)
- Aves Labs (378)
- Aviva (76426)
- BBI Solutions (174)
- BIO SB (3360)
- BMA Biomedicals (806)
- BT Lab (19660)
- Bio X Cell (1676)
- BioActs (64)
- BioAssay Works (20)
- BioChain Institute (35)
- BioPorto Diagnostics (236)
- BioServUK (71)
- BioTeZ (1)
- BioVendor (274)
- Biogenex (38)
- Biolegend (30316)
- Biomatik Corporation (24866)
- Biomedica (2)
- Biorbyt (1114355)
- Bioss (324359)
- Biosynth (41817)
- Biotium (45074)
- Bioworld Technology (34548)
- BlueGene (134)
- Boster Bio (144607)
- CH3 BioSystems (4)
- Cape Biologix Technologies (57)
- Caprico Biotechnologies (4284)
- Cedarlane (6300)
- Cell Biolabs (12)
- Chondrex (158)
- ChromaGenix (14)
- Cloud-Clone (27586)
- Columbia Biosciences (210)
- Concise Separations (114)
- Covalab (9948)
- Creative BioMart (108)
- Creative Biolabs (21145)
- Cusabio (68562)
- Cygnus Technologies (103)
- Cytognos (21)
- Cytoskeleton (62)
- DB-Biotech (483)
- DCS Diagnostics (92)
- DLDEVELOP (16705)
- ELK Biotechnology (11947)
- EXBIO (4580)
- EastCoast Bio (1430)
- Elabscience (16561)
- EnkiLife (19661)
- Enzo Life Sciences (2210)
- Everest (6868)
- FabGennix (4257)
- Fuller (41)
- GeneTex (40777)
- Genesee Scientific (89)
- GenomeMe (536)
- Genscript (7321)
- GenuIN Biotechnologies (7013)
- Green Mountain Antibodies (110)
- HUABIO (10079)
- HUMAN (1)
- HansaBioMed (12)
- HelloBio (55)
- Hycult (1177)
- IBA (3)
- ICL (721)
- IHC WORLD (75)
- ImmuQuest (514)
- ImmunoChemistry Technologies (22)
- ImmunoReagents (1045)
- Immunostep (392)
- Jackson ImmunoResearch (3775)
- KactusBio (8)
- Kamiya Biomedical Company (775)
- Kerafast (1177)
- Krishgen Biosystems (6)
- Lampire Biological Labs (578)
- Leadgene Biomedical (215)
- LifeSpan Biosciences (1007652)
- LifeTein (5)
- Linaris (5332)
- List Biological Labs (2)
- MABTECH (561)
- MBL (2191)
- MP Biomedicals Germany (174)
- MS Validated Antibodies (543)
- MaxVision Biosciences (1)
- MedSchenker (1)
- MedchemExpress (9333)
- Medix Biochemica (883)
- Mirus Bio (1)
- MoBiTec (7)
- Monosan (2358)
- MyBiosource (1554801)
- NABAS (23)
- NSJ Bioreagents (37697)
- NZYtech (4)
- NanoTag Biotechnologies (262)
- Nanoprobes (123)
- NeoBiotechnologies (17250)
- Neuromics (801)
- Nordic BioSite (404722)
- NordicMubio (2670)
- Oxford Biomedical Research (314)
- PBL Assay Science (51)
- Phosphosolutions (782)
- Poly-Dtech (37)
- ProSci (35743)
- ProSpec-Tany Technogene (749)
- Procell Biotechnology (20)
- ProteinArk (5)
- ProteoGenix (20469)
- RD-Biotech (7)
- RayBiotech (52547)
- Reed Biotech (783)
- Reprocell (3)
- RevMAb (457)
- Roboscreen (141)
- Rockland Immunochemicals (8987)
- Sanyou Bio (1553)
- Sceti (2809)
- ScyTek Laboratories (2072)
- Selleck (1)
- SignalChem Diagnostics (14)
- Sino Biological (205211)
- SouthernBiotech (3458)
- Statens Serum Institut (319)
- Svar Life Science (4)
- Synabs (1199)
- TOKU-E (11)
- The Native Antigen Company (656)
- Toronto Bioscience (56)
- Trevigen (21)
- U-CyTech biosciences (63)
- UBPBio, LLC (98)
- US Biological (334715)
- VITRO (191)
- Vazyme Biotech (3)
- Vector Biolabs (1)
- Vector Laboratories (88)
- ViroStat (1251)
- Virusys (91)
- Zytomed Systems (6871)
- dianova (1588)
- nanoimmunotech (4)
- reddot Biotech (20751)
Klon-Bezeichnung
- [cl0142] (2)
- [cl0143] (2)
- [cl0151] (1)
- [cl0157] (1)
- [cl0159] (1)
- [cl0160] (1)
- [cl0164] (1)
- [cl0166] (1)
- [cl0170] (1)
- [cl0171] (1)
- [cl0173] (1)
- [cl0176] (1)
- [cl0178] (2)
- [cl0182] (1)
- [cl0185] (1)
- [cl0186] (1)
- [cl0190] (1)
- [cl0197] (1)
- [cl0199] (1)
- [cl0201] (1)
- [cl0203] (1)
- [cl0206] (2)
- [cl0210] (1)
- [cl0213] (1)
- [cl0215] (1)
- [cl0216] (1)
- [cl0219] (1)
- [cl0223] (1)
- [cl0224] (1)
- [cl0225] (1)
- [cl0226] (1)
- [cl0232] (1)
- [cl0235] (1)
- [cl0236] (1)
- [cl0237] (1)
- [cl0239] (1)
- [cl0240] (1)
- [cl0241] (1)
- [cl0257] (2)
- [cl0259] (2)
- [cl0260] (2)
- [cl0262] (1)
- [cl0265] (1)
- [cl0268] (1)
- [cl0271] (1)
- [cl0273] (1)
- [cl0275] (1)
- [cl0276] (1)
- [cl0278] (1)
- [cl0280] (1)
- [cl0284] (1)
- [cl0285] (1)
- [cl0290] (1)
- [cl0296] (1)
- [cl0301] (1)
- [cl0303] (1)
- [cl0304] (1)
- [cl0305] (1)
- [cl0307] (1)
- [cl0308] (1)
- [cl0319] (1)
- [cl0320] (2)
- [cl0321] (1)
- [cl0323] (1)
- [cl0328] (1)
- [cl0331] (2)
- [cl0337] (1)
- [cl0339] (1)
- [cl0344] (1)
- [cl0345] (1)
- [cl0346] (1)
- [cl0347] (1)
- [cl0349] (1)
- [cl0351] (1)
- [cl0363] (1)
- [cl0364] (1)
- [cl0366] (1)
- [cl0368] (2)
- [cl0369] (1)
- [cl0370] (1)
- [cl0371] (1)
- [cl0374] (1)
- [cl0378] (2)
- [cl0381] (1)
- [cl0387] (1)
- [cl0395] (1)
- [cl0397] (1)
- [cl0401] (1)
- [cl0463] (1)
- [cl0465] (1)
- [cl0467] (1)
- [cl0468] (1)
- [cl0474] (2)
- [cl0485] (1)
- [cl0490] (1)
- [cl0492] (1)
- [cl0510] (2)
- [cl0524] (1)
- [cl0537] (1)
- [cl0538] (1)
- [cl0539] (1)
- [cl0542] (1)
- [cl0555] (1)
- [cl0575] (1)
- [cl0576] (1)
- [cl0580] (1)
- [cl0624] (1)
- [cl0628] (1)
- [cl0631] (1)
- [cl0639] (1)
- [cl0654] (1)
- [cl0665] (1)
- [cl0815] (1)
- [cl0822] (1)
- [cl0887] (1)
- [cl0899] (1)
- [cl10078] (1)
- [cl10130] (1)
- [cl10165] (1)
- [cl10252] (1)
- [cl10283] (1)
- [cl1028] (2)
- [cl10309] (1)
- [cl1040] (1)
- [cl10474] (1)
- [cl10543] (1)
- [cl10552] (1)
- [cl1057] (1)
- [cl10587] (1)
- [cl10591] (1)
- [cl10613] (1)
- [cl10622] (1)
- [cl10631] (1)
- [cl10632] (1)
- [cl1063] (1)
- [cl10652] (1)
- [cl10658] (1)
- [cl10662] (1)
- [cl10686] (1)
- [cl10697] (1)
- [cl10758] (1)
- [cl10765] (1)
- [cl1083] (1)
- [cl10847] (1)
- [cl10855] (1)
- [cl10884] (1)
- [cl10888] (1)
- [cl10930] (1)
- [cl10936] (1)
- [cl1095] (1)
- [cl10961] (1)
- [cl10962] (1)
- [cl10964] (1)
- [cl11023] (1)
- [cl1111] (1)
- [cl11132] (1)
- [cl1113] (1)
- [cl11142] (1)
- [cl11144] (1)
- [cl1115] (2)
- [cl11171] (1)
- [cl1118] (1)
- [cl11191] (1)
- [cl11214] (1)
- [cl11222] (2)
- [cl11225] (2)
- [cl1128] (1)
- [cl11293] (1)
- [cl11294] (1)
- [cl1129] (1)
- [cl11342] (1)
- [cl11357] (1)
- [cl11368] (1)
- [cl11380] (1)
- [cl11393] (1)
- [cl11404] (1)
- [cl11434] (1)
- [cl11463] (1)
- [cl11474] (1)
- [cl1147] (1)
- [cl11508] (1)
- [cl11547] (1)
- [cl11630] (1)
- [cl11651] (1)
- [cl11653] (1)
- [cl11661] (1)
- [cl11669] (1)
- [cl1170] (1)
- [cl11722] (1)
- [cl11723] (1)
- [cl1172] (1)
- [cl11773] (1)
- [cl1180] (1)
- [cl11865] (1)
- [cl11892] (1)
- [cl11896] (1)
- [cl11915] (1)
- [cl11945] (1)
- [cl11960] (1)
- [cl11968] (1)
- [cl1196] (1)
- [cl11981] (1)
- [cl11995] (1)
- [cl12064] (1)
- [cl12087] (1)
- [cl12090] (1)
- [cl12131] (1)
- [cl12180] (1)
- [cl12183] (1)
- [cl12185] (1)
- [cl12191] (1)
- [cl12192] (1)
- [cl12193] (1)
- [cl12241] (1)
- [cl12314] (1)
- [cl12323] (1)
- [cl12328] (1)
- [cl12334] (1)
- [cl1234] (1)
- [cl12420] (1)
- [cl12435] (1)
- [cl12448] (1)
- [cl1249] (1)
- [cl12511] (1)
- [cl12512] (1)
- [cl12514] (1)
- [cl12531] (1)
- [cl12632] (1)
- [cl12711] (1)
- [cl12732] (1)
- [cl12753] (1)
- [cl12762] (1)
- [cl12810] (1)
- [cl12822] (1)
- [cl12836] (1)
- [cl12838] (1)
- [cl12842] (1)
- [cl1284] (1)
- [cl12855] (1)
- [cl12863] (1)
- [cl12864] (1)
- [cl12874] (1)
- [cl12886] (1)
- [cl12917] (1)
- [cl12929] (1)
- [cl12954] (1)
- [cl12967] (1)
- [cl12974] (1)
- [cl12984] (1)
- [cl12988] (1)
- [cl13081] (1)
- [cl13128] (1)
- [cl13129] (1)
- [cl13130] (1)
- [cl13157] (1)
- [cl13165] (1)
- [cl13170] (1)
- [cl13176] (1)
- [cl13278] (1)
- [cl13318] (1)
- [cl13319] (1)
- [cl13324] (1)
- [cl13328] (1)
- [cl13332] (1)
- [cl13336] (1)
- [cl13358] (1)
- [cl13359] (1)
- [cl13382] (1)
- [cl1338] (1)
- [cl13403] (1)
- [cl13438] (1)
- [cl13467] (1)
- [cl1346] (1)
- [cl13472] (1)
- [cl13474] (1)
- [cl13501] (1)
- [cl13530] (1)
- [cl13563] (1)
- [cl13565] (1)
- [cl13567] (1)
- [cl13579] (1)
- [cl13589] (1)
- [cl13603] (1)
- [cl13618] (1)
- [cl13628] (2)
- [cl13683] (1)
- [cl13713] (1)
- [cl13724] (1)
- [cl13764] (1)
- [cl13779] (1)
- [cl13783] (1)
- [cl13808] (1)
- [cl13809] (1)
- [cl13814] (1)
- [cl13815] (1)
- [cl13841] (1)
- [cl13844] (1)
- [cl13859] (1)
- [cl13863] (1)
- [cl13956] (1)
- [cl13957] (1)
- [cl13965] (1)
- [cl13973] (1)
- [cl13992] (1)
- [cl14017] (1)
- [cl14031] (1)
- [cl14037] (1)
- [cl14039] (1)
- [cl14059] (1)
- [cl14064] (1)
- [cl14084] (1)
- [cl14096] (1)
- [cl14112] (1)
- [cl14114] (1)
- [cl14116] (1)
- [cl14122] (1)
- [cl14133] (1)
- [cl14164] (1)
- [cl14321] (1)
- [cl14332] (1)
- [cl14381] (1)
- [cl14436] (1)
- [cl14469] (1)
- [cl14471] (1)
- [cl14479] (1)
- [cl14486] (1)
- [cl14502] (1)
- [cl14523] (1)
- [cl14528] (1)
- [cl14531] (1)
- [cl14548] (1)
- [cl14550] (1)
- [cl14552] (1)
- [cl14556] (1)
- [cl14565] (1)
- [cl14568] (1)
- [cl14576] (1)
- [cl14579] (1)
- [cl14611] (1)
- [cl14612] (1)
- [cl14615] (1)
- [cl14617] (1)
- [cl14619] (1)
- [cl14627] (1)
- [cl1466] (1)
- [cl14693] (1)
- [cl14696] (1)
- [cl14707] (1)
- [cl14765] (1)
- [cl14773] (1)
- [cl14825] (1)
- [cl14976] (1)
- [cl1497] (2)
- [cl14991] (1)
- [cl15002] (1)
- [cl15024] (1)
- [cl15033] (1)
- [cl15043] (1)
- [cl15059] (1)
- [cl15060] (1)
- [cl15065] (1)
- [cl15070] (1)
- [cl15072] (1)
- [cl15073] (1)
- [cl15075] (1)
- [cl15076] (1)
- [cl15085] (1)
- [cl15190] (1)
- [cl15251] (1)
- [cl15257] (1)
- [cl15299] (1)
- [cl1529] (2)
- [cl15302] (1)
- [cl15308] (1)
- [cl15323] (1)
- [cl15329] (1)
- [cl15357] (1)
- [cl15364] (1)
- [cl15366] (1)
- [cl15368] (1)
- [cl15425] (1)
- [cl15426] (1)
- [cl15454] (1)
- [cl15459] (1)
- [cl15464] (1)
- [cl1546] (1)
- [cl15513] (1)
- [cl15523] (1)
- [cl15542] (1)
- [cl1555] (2)
- [cl15572] (1)
- [cl15606] (1)
- [cl15622] (1)
- [cl15628] (1)
- [cl1567] (1)
- [cl1608] (1)
- [cl1637] (1)
- [cl1638] (1)
- [cl1656] (1)
- [cl1657] (1)
- [cl1667] (1)
- [cl1673] (1)
- [cl1679] (1)
- [cl1685] (1)
- [cl1719] (1)
- [cl1831] (1)
- [cl1858] (1)
- [cl1912] (1)
- [cl1950] (1)
- [cl1957] (1)
- [cl2148] (1)
- [cl2155] (1)
- [cl2162] (1)
- [cl2199] (1)
- [cl2209] (1)
- [cl2220] (1)
- [cl2237] (1)
- [cl2240] (1)
- [cl2242] (2)
- [cl2243] (1)
- [cl2245] (1)
- [cl2287] (1)
- [cl2302] (1)
- [cl2304] (1)
- [cl2309] (1)
- [cl2310] (1)
- [cl2360] (1)
- [cl2375] (1)
- [cl2378] (1)
- [cl2384] (1)
- [cl2433] (1)
- [cl2435] (2)
- [cl2444] (2)
- [cl2446] (1)
- [cl2452] (1)
- [cl2502] (1)
- [cl2522] (1)
- [cl2524] (2)
- [cl2545] (1)
- [cl2548] (1)
- [cl2553] (1)
- [cl2561] (1)
- [cl2579] (1)
- [cl2593] (1)
- [cl2596] (1)
- [cl2603] (1)
- [cl2610] (1)
- [cl2647] (2)
- [cl2650] (1)
- [cl2660] (1)
- [cl2662] (1)
- [cl2663] (1)
- [cl2671] (1)
- [cl2678] (1)
- [cl2688] (1)
- [cl2697] (1)
- [cl2705] (1)
- [cl2713] (2)
- [cl2720] (1)
- [cl2736] (1)
- [cl2754] (1)
- [cl2782] (1)
- [cl2783] (1)
- [cl2793] (1)
- [cl2819] (1)
- [cl2827] (1)
- [cl2829] (2)
- [cl2852] (2)
- [cl2858] (1)
- [cl2871] (1)
- [cl2872] (1)
- [cl2887] (1)
- [cl2911] (1)
- [cl2914] (1)
- [cl2919] (1)
- [cl2921] (2)
- [cl2952] (1)
- [cl2962] (2)
- [cl2968] (1)
- [cl2970] (1)
- [cl2976] (1)
- [cl2979] (1)
- [cl2980] (2)
- [cl2990] (1)
- [cl2999] (1)
- [cl3004] (1)
- [cl3013] (1)
- [cl3049] (1)
- [cl3063] (2)
- [cl3087] (2)
- [cl3112] (1)
- [cl3118] (1)
- [cl3123] (1)
- [cl3169] (1)
- [cl3173] (2)
- [cl3183] (1)
- [cl3185] (1)
- [cl3195] (1)
- [cl3196] (2)
- [cl3199] (1)
- [cl3201] (1)
- [cl3202] (1)
- [cl3210] (1)
- [cl3265] (2)
- [cl3266] (1)
- [cl3299] (1)
- [cl3301] (1)
- [cl3353] (2)
- [cl3363] (1)
- [cl3392] (1)
- [cl3423] (2)
- [cl3450] (1)
- [cl3482] (1)
- [cl3484] (1)
- [cl3497] (1)
- [cl3501] (1)
- [cl3515] (1)
- [cl3524] (1)
- [cl3573] (1)
- [cl3576] (1)
- [cl3580] (1)
- [cl3595] (1)
- [cl3624] (1)
- [cl3638] (1)
- [cl3640] (1)
- [cl3689] (1)
- [cl3691] (1)
- [cl3698] (1)
- [cl3700] (2)
- [cl3708] (1)
- [cl3716] (1)
- [cl3730] (1)
- [cl3748] (1)
- [cl3760] (1)
- [cl3770] (1)
- [cl3771] (1)
- [cl3805] (1)
- [cl3807] (1)
- [cl3868] (1)
- [cl3901] (1)
- [cl3915] (1)
- [cl3929] (1)
- [cl3975] (1)
- [cl3981] (1)
- [cl3989] (1)
- [cl3991] (1)
- [cl4003] (1)
- [cl4004] (1)
- [cl4013] (1)
- [cl4035] (2)
- [cl4045] (2)
- [cl4046] (1)
- [cl4049] (1)
- [cl4164] (1)
- [cl4233] (1)
- [cl4252] (1)
- [cl4254] (1)
- [cl4265] (1)
- [cl4270] (1)
- [cl4281] (1)
- [cl4289] (1)
- [cl4290] (1)
- [cl4438] (1)
- [cl4455] (1)
- [cl4463] (1)
- [cl4472] (1)
- [cl4489] (1)
- [cl4490] (1)
- [cl4501] (1)
- [cl4502] (1)
- [cl4540] (1)
- [cl4681] (1)
- [cl4688] (1)
- [cl4716] (1)
- [cl4725] (1)
- [cl4729] (1)
- [cl4762] (2)
- [cl4844] (1)
- [cl4851] (1)
- [cl4881] (1)
- [cl4888] (1)
- [cl4906] (1)
- [cl4917] (1)
- [cl4923] (1)
- [cl4967] (1)
- [cl4968] (1)
- [cl5039] (1)
- [cl5041] (1)
- [cl5048] (1)
- [cl5101] (1)
- [cl5146] (1)
- [cl5148] (1)
- [cl5157] (1)
- [cl5245] (1)
- [cl5256] (1)
- [cl5263] (1)
- [cl5275] (1)
- [cl5278] (2)
- [cl5287] (1)
- [cl5289] (2)
- [cl5306] (2)
- [cl5310] (1)
- [cl5312] (2)
- [cl5324] (1)
- [cl5339] (1)
- [cl5346] (1)
- [cl5414] (1)
- [cl5420] (2)
- [cl5568] (1)
- [cl5634] (1)
- [cl5665] (1)
- [cl5685] (1)
- [cl5690] (1)
- [cl5692] (1)
- [cl5695] (1)
- [cl5782] (1)
- [cl5785] (1)
- [cl5803] (1)
- [cl5810] (1)
- [cl5813] (2)
- [cl5814] (1)
- [cl5817] (1)
- [cl5818] (1)
- [cl5950] (1)
- [cl6137] (1)
- [cl6228] (1)
- [cl6232] (1)
- [cl6251] (2)
- [cl6259] (1)
- [cl6313] (1)
- [cl6334] (1)
- [cl6365] (1)
- [cl6381] (1)
- [cl6426] (1)
- [cl6491] (1)
- [cl6501] (1)
- [cl6526] (2)
- [cl6528] (1)
- [cl6550] (1)
- [cl6553] (1)
- [cl6559] (1)
- [cl6607] (1)
- [cl6629] (1)
- [cl6873] (2)
- [cl6913] (1)
- [cl6915] (1)
- [cl6916] (1)
- [cl6937] (1)
- [cl6940] (1)
- [cl6945] (1)
- [cl6951] (1)
- [cl6957] (1)
- [cl6972] (1)
- [cl6973] (1)
- [cl7067] (1)
- [cl7084] (1)
- [cl7111] (1)
- [cl7207] (1)
- [cl7217] (1)
- [cl7290] (1)
- [cl7304] (1)
- [cl7318] (1)
- [cl7319] (1)
- [cl7621] (1)
- [cl7628] (1)
- [cl7716] (1)
- [cl7721] (1)
- [cl7787] (1)
- [cl7834] (1)
- [cl7919] (1)
- [cl7935] (1)
- [cl7990] (1)
- [cl8102] (1)
- [cl8121] (1)
- [cl8203] (1)
- [cl8228] (1)
- [cl8266] (1)
- [cl8345] (1)
- [cl8347] (1)
- [cl8360] (1)
- [cl8472] (1)
- [cl8660] (1)
- [cl8714] (1)
- [cl8721] (1)
- [cl8723] (1)
- [cl8725] (1)
- [cl8733] (1)
- [cl8892] (1)
- [cl8961] (1)
- [cl8994] (1)
- [cl9025] (1)
- [cl9032] (1)
- [cl9071] (1)
- [cl9089] (1)
- [cl9091] (1)
- [cl9101] (1)
- [cl9148] (1)
- [cl9175] (1)
- [cl9255] (1)
- [cl9297] (1)
- [cl9360] (1)
- [cl9362] (1)
- [cl9390] (1)
- [cl9414] (1)
- [cl9422] (1)
- [cl9440] (1)
- [cl9469] (2)
- [cl9499] (1)
- [cl9500] (1)
- [cl9503] (1)
- [cl9508] (1)
- [cl9518] (1)
- [cl9662] (1)
- [cl9714] (1)
- [cl9744] (1)
- [cl9747] (1)
- [cl9766] (1)
- [cl9772] (1)
- [cl9774] (1)
- [cl9956] (1)
Anti-CBX2
- Bilder: 9
- Applikation: 2
| Artikelnummer: | ATA-HPA023083 |
| Hersteller: | Atlas Antibodies |
| Applikation: | ICC, IHC |
| Kategorie: | Antikörper |
| Menge: | 100 ul, 25 ul |
| Preise anzeigen | |









(9) Bilder
Anti-EIF3H
- Bilder: 9
- Applikation: 3
| Artikelnummer: | ATA-HPA023117 |
| Hersteller: | Atlas Antibodies |
| Applikation: | ICC, IHC, WB |
| Kategorie: | Antikörper |
| Menge: | 100 ul, 25 ul |
| Preise anzeigen | |









(9) Bilder
Anti-GRPEL2
- Bilder: 9
- Applikation: 3
| Artikelnummer: | ATA-HPA023211 |
| Hersteller: | Atlas Antibodies |
| Applikation: | ICC, IHC, WB |
| Kategorie: | Antikörper |
| Menge: | 100 ul, 25 ul |
| Preise anzeigen | |









(9) Bilder
Anti-GSDMA
- Bilder: 9
- Applikation: 1
| Artikelnummer: | ATA-HPA023313 |
| Hersteller: | Atlas Antibodies |
| Applikation: | IHC |
| Kategorie: | Antikörper |
| Menge: | 100 ul, 25 ul |
| Preise anzeigen | |









(9) Bilder
Anti-CCDC43
- Bilder: 9
- Applikation: 3
| Artikelnummer: | ATA-HPA023391 |
| Hersteller: | Atlas Antibodies |
| Applikation: | ICC, IHC, WB |
| Kategorie: | Antikörper |
| Menge: | 100 ul, 25 ul |
| Preise anzeigen | |









(9) Bilder
Anti-SCRIB
- Bilder: 9
- Applikation: 2
| Artikelnummer: | ATA-HPA023557 |
| Hersteller: | Atlas Antibodies |
| Applikation: | ICC, WB |
| Kategorie: | Antikörper |
| Menge: | 100 ul, 25 ul |
| Preise anzeigen | |









(9) Bilder
Anti-UBE2O
- Bilder: 9
- Applikation: 2
| Artikelnummer: | ATA-HPA023605 |
| Hersteller: | Atlas Antibodies |
| Applikation: | ICC, WB |
| Kategorie: | Antikörper |
| Menge: | 100 ul, 25 ul |
| Preise anzeigen | |









(9) Bilder
Anti-ESRP1
- Bilder: 9
- Applikation: 2
| Artikelnummer: | ATA-HPA023719 |
| Hersteller: | Atlas Antibodies |
| Applikation: | IHC, WB |
| Kategorie: | Antikörper |
| Menge: | 100 ul, 25 ul |
| Preise anzeigen | |

(9) Bilder
Anti-CASK
- Bilder: 9
- Applikation: 2
| Artikelnummer: | ATA-HPA023857 |
| Hersteller: | Atlas Antibodies |
| Applikation: | ICC, IHC |
| Kategorie: | Antikörper |
| Menge: | 100 ul, 25 ul |
| Preise anzeigen | |









(9) Bilder
Anti-DEPTOR
- Bilder: 9
- Applikation: 2
| Artikelnummer: | ATA-HPA023938 |
| Hersteller: | Atlas Antibodies |
| Applikation: | IHC, WB |
| Kategorie: | Antikörper |
| Menge: | 100 ul, 25 ul |
| Preise anzeigen | |

(9) Bilder




 Ein typischer Immunassay wird zunächst mit einem Blocking-Reagenz inkubiert um unspezifische Bindungen zu minimieren. Anschließend wird der primäre Antikörper hinzugefügt, der spezifisch an das Ziel-Antigen bindet. Nach dem Auswaschen etwaiger ungebundener Antikörper, wird ein Sekundärantikörper zur Detektion verwendet. Sekundärantikörper sind meist Anti-Spezies-Antikörper gegen den Wirt, in welchem der Primärantikörper generiert wurde, und üblicherweise mit einem Farbstoff oder Enzym gekoppelt, um die Anwesenheit des detektierten Antigens in der Probe sichtbar zu machen.
Ein typischer Immunassay wird zunächst mit einem Blocking-Reagenz inkubiert um unspezifische Bindungen zu minimieren. Anschließend wird der primäre Antikörper hinzugefügt, der spezifisch an das Ziel-Antigen bindet. Nach dem Auswaschen etwaiger ungebundener Antikörper, wird ein Sekundärantikörper zur Detektion verwendet. Sekundärantikörper sind meist Anti-Spezies-Antikörper gegen den Wirt, in welchem der Primärantikörper generiert wurde, und üblicherweise mit einem Farbstoff oder Enzym gekoppelt, um die Anwesenheit des detektierten Antigens in der Probe sichtbar zu machen. 


